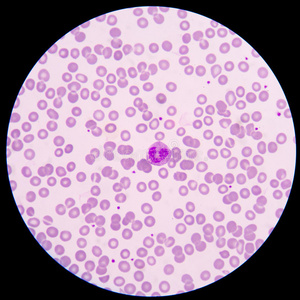
记事本与文本标签血癌 实验室试管的血,血液涂片在显微镜和血在医生桌

血液图片 显微镜

三个人的血在显微镜下的样子,哪个血最好?猜对有奖
图片尺寸1713x1280
三个人的血在显微镜下的样子,哪个血最好?猜对有奖
图片尺寸1782x1280
在显微镜下观察自己的血液
图片尺寸1072x603
光学显微镜观察血液有何注意事项
图片尺寸1536x2048
科普一下 #血液里面有什么 #显微镜下的世 - 抖音
图片尺寸1440x1440
人教版七年级下册生物第四单元第四章第一节流动的组织血液课件共18张
图片尺寸720x540近距离微距显微镜下白色背景的血液样本
图片尺寸800x1200血液在显微镜下
图片尺寸1200x901
血液在显微镜下是什么样的?检验师带你走进微观世界
图片尺寸298x305
血液在显微镜下是什么样的?检验师带你走进微观世界
图片尺寸257x260
显微镜94下的人血涂片 图一图二 低倍镜 图三图四 高倍镜 图中
图片尺寸1920x2560
光学显微镜观察血液有何注意事项
图片尺寸2048x1536
三个人的血在显微镜下的样子,哪个血最好?猜对有奖
图片尺寸1738x1280
光学显微镜观察血液有何注意事项
图片尺寸1920x1080
人血涂片生物显微镜标本切片红细胞白细胞显像清晰易观察显微玻片 人
图片尺寸350x350白血病患者血液涂片的显微镜观察
图片尺寸1100x1100
记事本与文本标签血癌 实验室试管的血,血液涂片在显微镜和血在医生桌
图片尺寸300x300
血液.
图片尺寸2048x1536白血病患者血液涂片的显微镜视图
图片尺寸1200x600
显微镜下的血液形态
图片尺寸1152x720
猜你喜欢:血液图片健康的血液图片血液粘稠严重图片血液图片显微镜血液显微镜下图片人血涂片显微镜图片显微镜看血液图谱显微镜下血液粘稠图片显微镜下血液细胞图显微镜看血液血液显微镜显微镜下的血细胞图片显微镜图片结构图显微镜下血液显微镜下的血液细菌图片显微镜显微镜下的血脂稠图片显微镜下的血液垃圾图显微镜图片鞭毛显微镜下图片荚膜显微镜下图片显微镜看血液骗局照片显微镜图片卡通细菌图片显微镜病毒显微镜图片植物细胞血液粘稠血脂高图片血液图片背景血液图片白细胞血液图片黏稠血液图片恐怖车照片大全图片 家用女性大腿内侧地方绝味鸭心价格小孩牙龈发黑发紫图片方琼年轻cable ladder大丰杨超越冲锋队队旗爱马仕翻糖蛋糕入盆前后的图片对比巨人简笔画 儿童刷牙图画